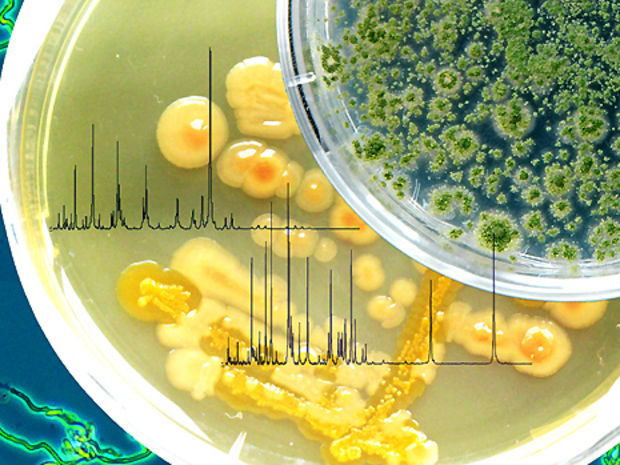

Salmonellen, Schimmelpilze, EHEC und andere krankmachende Erreger auf Frisch-produkten können künftig einfacher und schneller identifiziert werden. Zusammen mit dem Functional Genomics Center Zurich arbeitet die Forschung-sanstalt Agroscope Changins-Wädenswil an einer neuen Erkennungs-methode.
Krankheitserregende Bakterien auf pflanzlichen Frischprodukten haben von Mai bis Juli dieses Jahres europaweit für Schlagzeilen gesorgt. 3842 Erkrankte allein in Deutschland - darunter 53 Todesfälle - waren die traurige Bilanz. In der Gemüsebranche kam es ferner zu Umsatzeinbussen.
Praxistauglichkeit im Test
Experten der Forschungsanstalt Agroscope Changins-Wädenswil (ACW) arbeiten haben zusammen mit Fachleuten des Functional Genomics Center Zurich (FGCZ) der ETH und der Universität Zürich eine neue Methode entwickelt, um solche Erreger schnell und zugleich genau identifizieren zu können, wie es in einer ACW-Mitteilung vom Donnerstag heisst.
Die neue Methode befindet sich nach Auskunft von David Drissner, Leiter der ACW-Forschungsgruppe Lebensmittelmikrobiologie, derzeit in der Testphase. Sie habe sich bisher als sehr erfolgreich erwiesen. Grossverteiler und andere Interessierte werden sie in Zukunft selbst ganz oder teilweise anwenden können - je nach deren Bereitschaft, ihre Labors mit den entsprechenden Geräten auszurüsten.
Für bakterielle wie pilzliche Erreger geeignet
Im Mittelpunkt stehen nach der ACW-Mitteilung Erreger, die bereits in verschiedenen Ländern zu Krankheitsausbrüchen bei roh verzehrten pflanzlichen Produkten geführt haben.
Die Methode eignet sich dazu, sowohl bakterielle als auch pilzliche Erreger zu identifizieren. Dabei macht sie sich typische Eiweisse der Krankheitserreger zunutze, die als so genannte Protein-Fingerabdrücke dargestellt werden können.
Fahnden nach dem Ursprung des Erregers
Der Test soll nicht nur anzeigen können, welcher Art ein Keim angehört, sondern auch welcher Unterart und sogar welchem Stamm - denn genau dies ist entscheidend, um sagen zu können, ob der gefundene Keim zu einer Variante gehört, die bei Menschen Krankheiten auslöst oder nicht.
Darüber hinaus soll die neue Methode mithelfen, herauszufinden, woher Krankheitskeime kommen - ob sie im Anbau, durch die Bewässerung, mit der Düngung, bei der Verarbeitung oder während der Lagerung die Früchte und Gemüse kontaminiert haben.